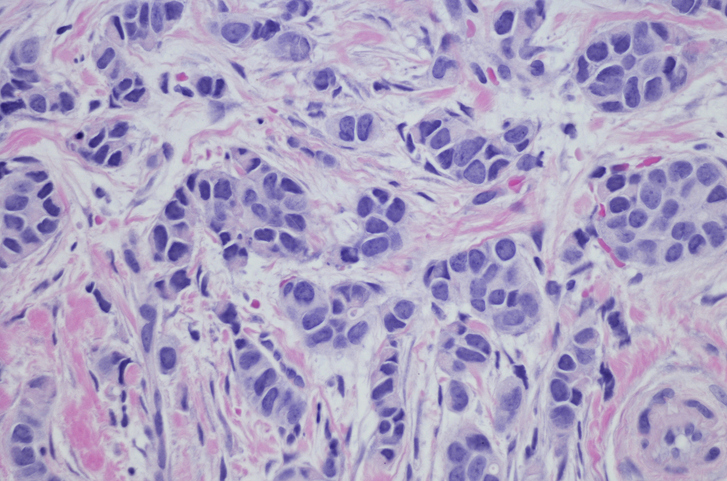
...

Breast cancer subtype could be rising
A study has uncovered trends in the incidence of the breast cancer subtype invasive lobular carcinoma.
In a study published in Cancer, investigators used data from the National Program of Cancer Registries and the Surveillance, Epidemiology and End Results Program to analyze the incidence rates of invasive lobular carcinoma.
The investigators found that the rates of invasive lobular carcinoma increased by about 3% per year from 2012 to 2021. The cancer type accounted for about 11% of invasive breast cancer cases between 2017 and 2021 and was more common among patients aged 65 years and older.
The investigators concluded that differentiating invasive lobular carcinoma from other invasive breast cancers may be critical to identifying the most effective treatment strategies and improving patient outcomes.
Read more: Cancer
The article presented here is intended to inform you about the broader media perspective on dentistry, regardless of its alignment with the ADA's stance. It is important to note that publication of an article does not imply the ADA's endorsement, agreement, or promotion of its content.